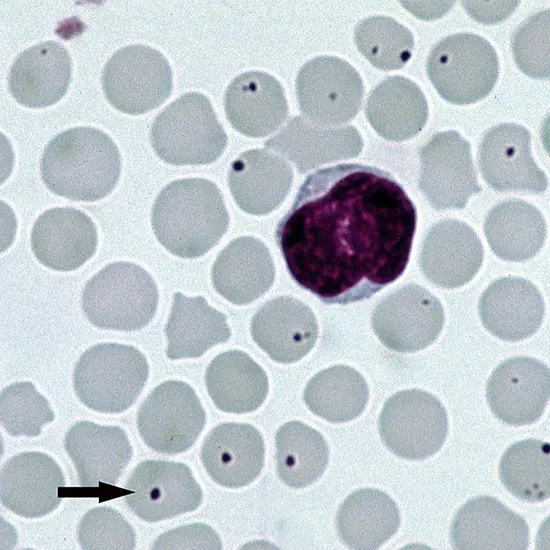
Human Granulocytic Anaplasmosis

Book Human Granulocytic Anaplasmosis Appointment Online Near me at the best price in Delhi/NCR from Ganesh Diagnostic. NABL & NABH Accredited Diagnostic centre and Pathology lab in Delhi offering a wide range of Radiology & Pathology tests. Get Free Ambulance & Free Home Sample collection. 24X7 Hour Open. Call Now at 011-47-444-444 to Book your Human Granulocytic Anaplasmosis at 50% Discount.
Human granulocytic anaplasmosis (HGA), also known as human granulocytic ehrlichiosis (HGE), is a tick-borne bacterial infection caused by the bacterium Anaplasma phagocytophilum. It is transmitted to humans through the bite of infected ticks, primarily the black-legged tick (Ixodes scapularis) in the United States, which is also a vector for Lyme disease.
HGA typically presents with non-specific flu-like symptoms, which may include fever, headache, muscle aches, chills, fatigue, and sometimes gastrointestinal symptoms such as nausea, vomiting, and diarrhea. In some cases, more severe symptoms such as respiratory distress, rash, and neurological manifestations may occur.
Diagnosis of HGA is typically based on clinical evaluation, medical history, and laboratory tests. Blood tests, such as polymerase chain reaction (PCR) or serologic testing, can be used to detect the presence of Anaplasma phagocytophilum bacteria in the blood, and can help confirm the diagnosis.
| CBC | 175 | |
| Stool Routine Examination and Microscopy | 250 | |
| KFT | 400 | |
| Alanine Aminotransferase (ALT, or SGPT) | 125 | |
| Ultrasound Whole Abdomen | 1000 | |
| X Ray Chest | 225 | |
| CECT Chest | 3500 | |
| CECT Abdomen | 4200 | |
| Test Price | 9875 |
| Test Type | Human Granulocytic Anaplasmosis |
| Includes | Human Granulocytic Anaplasmosis (Common Diseases) |
| Preparation | |
| Reporting | Within 24 hours* |
| Test Price |
₹ 19750
|

Early check ups are always better than delayed ones. Safety, precaution & care is depicted from the several health checkups. Here, we present simple & comprehensive health packages for any kind of testing to ensure the early prescribed treatment to safeguard your health.